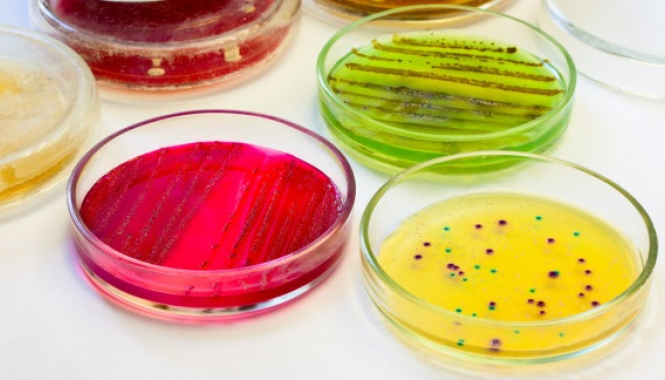
Бак. посевы

Методом бактериального посева (культуральный метод) можно качественно и количественно определить живую патогенную и
В большинстве анализов при выявлении достаточного количества патогенных микроорганизмов проводится определение их чувствительности (устойчивости) к ряду антибиотиков, антимикотических препаратов или бактериофагам.
Для сдачи анализов — не требуется запись. Анализы сдаются в порядке живой очереди в любом медцентре МедЛаб.